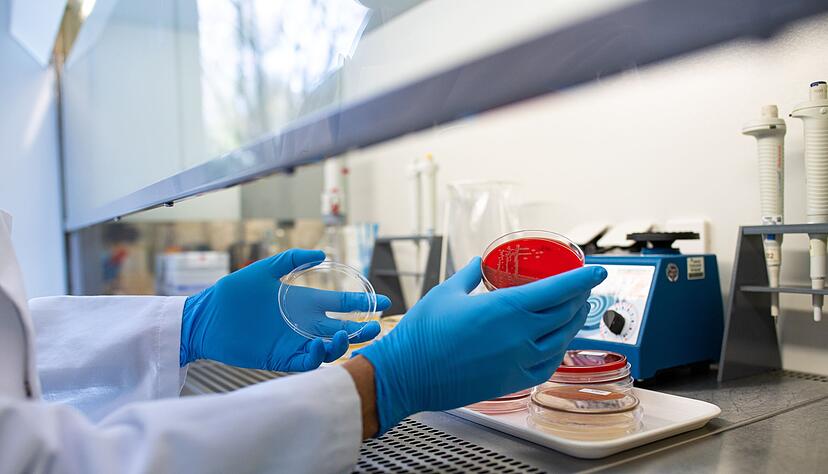
Die Zahl der registrierten Ehec-Infektionen in Mecklenburg-Vorpommern hat sich auf 17 erh&ouml;ht. (Archivbild)

Zahl der Ehec-Infektionen in MV steigt - Einsatz in Kita
Die Zahl der Ehec-Infektionen in Mecklenburg-Vorpommern wächst weiter. Ob auch Kinder einer Kita betroffen sind, ist unklar. Vorsorglich wurde aber entschieden gehandelt.

Die Zahl der bestätigten Ehec-Infektionen in Mecklenburg-Vorpommern hat sich weiter erhöht. Wie das Landesamt für Gesundheit und Soziales (Lagus) am Freitag in Rostock mitteilte, kamen 5 weitere Fälle hinzu, so dass nun insgesamt 17 Menschen betroffen sind. Zum Großteil handelt es sich um Kinder und Jugendliche im Alter zwischen 1 und 15 Jahren. Die Infektionsquellen und -wege sind weiterhin unklar.
Proben aus Kita noch in der Auswertung
Angesicht der Häufung von Ehec-Fällen im Osten Mecklenburg-Vorpommerns besteht der Verdacht, dass sich die toxinbildenden Bakterien weiter in Richtung Westen ausgebreitet haben könnten. Nachdem bei elf Kleinkindern in Kavelstorf bei Rostock starkes Erbrechen und vereinzelt auch Durchfall festgestellt worden war, wurden diese per Rettungswagen vorsorglich aus der Kita direkt in die Notaufnahme der Kinderklink in Rostock gebracht.
Ob es sich in Kavelstorf tatsächlich um Ehec- oder etwa weniger gefährliche Norovirus-Infektionen handelt, stand zunächst nicht fest. Die Proben seien noch in der Auswertung, Ergebnisse seien frühestens für Samstag zu erwarten, hieß es. Fünf der Kita-Kinder blieben nach Angaben der Kreisverwaltung in stationärer Behandlung, da sie starke Dehydrierungserscheinungen zeigten und stabilisiert werden müssten.
Auch wieder zwei Urlauber-Kinder betroffen
Unter den bestätigten Neuerkrankungen sind nach Angaben des Landesgesundheitsamtes vier Kinder im Alter von 1 bis 12 Jahren. Zwei von ihnen würden in Krankenhäusern stationär behandelt. Hinzu komme ein Ehec-Fall bei einer erwachsenen Person, die wie zwei der betroffenen Kinder aus Vorpommern stamme. Die anderen beiden Kinder kommen laut Lagus aus anderen Bundesländern und weilten mit ihren Familien zum Urlaub im Nordosten.
Wie das Gesundheitsamt weiter mitteilte, weisen nun insgesamt sechs der Kinder ein hämolytisch-urämisches Syndrom (HUS) auf. Da dies zur Zerstörung der roten Blutkörperchen, Blutgerinnungsstörungen und Funktionsstörungen der Nieren führen kann, werden die Betroffenen in der Regel intensivmedizinisch versorgt. Drei von ihnen mussten an eine Dialyse.
Normalerweise würden in MV pro Jahr ein oder zwei Ehec-Fälle mit HUS registriert, aber nicht so viele in relativ kurzer Zeit mit teils schweren Verläufen, sagte Martina Littmann, Leiterin der Abteilung Gesundheit beim Lagus. «Da gehen schon die Alarmglocken an.» Es gebe aber keinen Grund für Panik, betonte sie.
RKI: Keine Hinweise auf flächendeckende Häufung von Fällen
Das Robert Koch-Institut (RKI) sieht aktuell keine Hinweise auf eine Häufung von Ehec-Fällen in anderen Regionen Deutschlands. Gleiches gelte für das sogenannte hämolytisch-urämische Syndrom (HUS), sagte eine Sprecherin. Das RKI beobachte die Situation aber weiter sehr genau. Ein Expertenteam aus dem Bereich der Infektionsepidemiologie stehe in engem Kontakt mit den lokalen Gesundheitsbehörden.
Aktuell sorgen auch in Belgien Ehec-Infektionen für Aufsehen. In Seniorenheimen dort sind etwa 20 Menschen erkrankt. Der Nachrichtenagentur Belga zufolge starben bislang fünf von ihnen.
Kinder besonders gefährdet
Ehec steht für enterohämorrhagische Escherichia coli und bezeichnet bestimmte krankmachende Stämme dieses Darm-Bakteriums, das vor allem bei Wiederkäuern vorkommt. Die Mikroben produzieren sogenannte Shigatoxine: starke Zellgifte, die bei Menschen schwere Durchfallerkrankungen bis hin zu blutigen Durchfällen sowie HUS verursachen können. Kinder sind besonders gefährdet, weil ihr Immunsystem und ihre Organe noch nicht ausgereift sind.
Die Krankheitserreger können direkt oder indirekt von Tieren auf den Menschen übertragen werden. Eine Ansteckung von Mensch zu Mensch ist über eine Schmierinfektion möglich. Vom Verzehr eines verunreinigten Lebensmittels bis zum Ausbruch der Erkrankung dauert es im Durchschnitt drei bis vier Tage, wie es beim Bundesinstitut für Risikobewertung (BfR) heißt. Schon wenige Bakterien reichen aus, um eine Infektion anzustoßen. Ehec ist meldepflichtig.

Stimme.de
Stimme.de
Kommentare